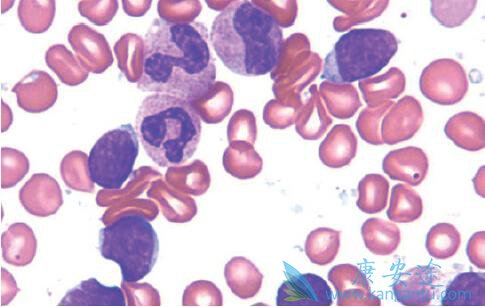

分配到治疗经历了更大的改善基线症状淋巴瘤患者有优越的具体问题,与健康相关的生活质量。该结果是基于患者报告的结局从功能评估癌症治疗淋巴瘤(factlym),其中包括FACT-G加上莱科思的分量,和eq-5d-5l问卷评估症状,幸福,健康,与健康相关的生活质量的患者的治疗。在factlym分量表,62%例患者对ibrutinib temsirolimus的36%相比有至少5点从基线的变化。Ibrutinib的三分之二例患者经历了在factlym总得分至少5分的有临床意义的改善。给患者的eq-5d-5l ibrutinib看到实用价值的改进基线在所有时间点为17周期相比,研究人员说,表明在与健康相关的生活质量普遍提高。相比之下,在成本与时间点的手臂患者基线比较负面的变化。FACT-G评估总体幸福感而factlyms措施与淋巴瘤患者的具体问题。eq-5d-5l包括5项问卷流动、自理、日常活动、疼痛/不适,焦虑/抑郁和视觉模拟量表(VAS)确定总体幸福感。
分配到治疗经历了更大的改善基线症状淋巴瘤患者有优越的具体问题,与健康相关的生活质量。该结果是基于患者报告的结局从功能评估癌症治疗淋巴瘤(factlym),其中包括FACT-G加上莱科思的分量,和eq-5d-5l问卷评估症状,幸福,健康,与健康相关的生活质量的患者的治疗。在factlym分量表,62%例患者对ibrutinib temsirolimus的36%相比有至少5点从基线的变化。Ibrutinib的三分之二例患者经历了在factlym总得分至少5分的有临床意义的改善。给患者的eq-5d-5l ibrutinib看到实用价值的改进基线在所有时间点为17周期相比,研究人员说,表明在与健康相关的生活质量普遍提高。相比之下,在成本与时间点的手臂患者基线比较负面的变化。FACT-G评估总体幸福感而factlyms措施与淋巴瘤患者的具体问题。eq-5d-5l包括5项问卷流动、自理、日常活动、疼痛/不适,焦虑/抑郁和视觉模拟量表(VAS)确定总体幸福感。 “这一研究结果显示,治疗可以减轻症状,并维持和恢复健康,健康状况和健康相关的生活质量在复发/难治性MCL患者,写道:”赫斯等人。“将患者的主观经验和观点纳入临床试验的结果可以为临床终点提供重要的补充,为临床医生和患者评估时要考虑治疗的风险效益平衡–提供额外的信息。”Ibrutinib是更好的耐受性比成本,具有优越的不良事件(AE)简介尽管长时间的暴露(14.4个月vs 3个月)。研究人员收集factlym和eq-5d-5l反应从MCL患者在门诊开始之前访问任何程序或医生的相互作用。问卷调查,在每个周期的1天,在前6个月,然后每9个星期到15个月后的第一个剂量的药物的研究。在这一点上,研究人员收集患者报告的临床结局每24周。事实情况给药直至疾病进展或死亡,临床截止,和eq-5d-5l给药直到研究结束,死亡,或临床截止。疾病进展后,研究人员eq-5d-5l每隔9周,高达3次,随访期间的生存,除非死亡,研究结束时,或临床截止首先发生。服用ibrutinib后跨越temsirolimus患者问卷调查收集直到停止治疗。总的来说,分配给那些分配到成本提供基线factlym反应治疗87%例94%。其实莱科思的分量,fact-pwb的平均差异和试验结局指数评分治疗组之间差异显著,通过至少11个周期的治疗,表明ibrutinib患者更大的改善,从基线为总体幸福感与淋巴瘤的具体问题。试验结果的指数是一个综合指数,由FACT-G健康域计算(fact-pwb),功能性健康领域(fact-fwb),而事实上莱科思量表。每5q-5d-5l VAS评价患者对ibrutinib报道改善其总体幸福感与日益恶化的健康人分配到成本比较。为从基线的变化ibrutinib VAS值从成本正和不同的统计时间点的前20周。与此相反,VAS评分从基线的变化对成本负在所有的时间点。接收成本已经从基线始终较低的效用和VAS值患者。研究人员发现,eq-5d-5l没有返回值在替西罗莫司组的基线水平,并始终低于那些在治疗组在任何时间点上周期14。
“这一研究结果显示,治疗可以减轻症状,并维持和恢复健康,健康状况和健康相关的生活质量在复发/难治性MCL患者,写道:”赫斯等人。“将患者的主观经验和观点纳入临床试验的结果可以为临床终点提供重要的补充,为临床医生和患者评估时要考虑治疗的风险效益平衡–提供额外的信息。”Ibrutinib是更好的耐受性比成本,具有优越的不良事件(AE)简介尽管长时间的暴露(14.4个月vs 3个月)。研究人员收集factlym和eq-5d-5l反应从MCL患者在门诊开始之前访问任何程序或医生的相互作用。问卷调查,在每个周期的1天,在前6个月,然后每9个星期到15个月后的第一个剂量的药物的研究。在这一点上,研究人员收集患者报告的临床结局每24周。事实情况给药直至疾病进展或死亡,临床截止,和eq-5d-5l给药直到研究结束,死亡,或临床截止。疾病进展后,研究人员eq-5d-5l每隔9周,高达3次,随访期间的生存,除非死亡,研究结束时,或临床截止首先发生。服用ibrutinib后跨越temsirolimus患者问卷调查收集直到停止治疗。总的来说,分配给那些分配到成本提供基线factlym反应治疗87%例94%。其实莱科思的分量,fact-pwb的平均差异和试验结局指数评分治疗组之间差异显著,通过至少11个周期的治疗,表明ibrutinib患者更大的改善,从基线为总体幸福感与淋巴瘤的具体问题。试验结果的指数是一个综合指数,由FACT-G健康域计算(fact-pwb),功能性健康领域(fact-fwb),而事实上莱科思量表。每5q-5d-5l VAS评价患者对ibrutinib报道改善其总体幸福感与日益恶化的健康人分配到成本比较。为从基线的变化ibrutinib VAS值从成本正和不同的统计时间点的前20周。与此相反,VAS评分从基线的变化对成本负在所有的时间点。接收成本已经从基线始终较低的效用和VAS值患者。研究人员发现,eq-5d-5l没有返回值在替西罗莫司组的基线水平,并始终低于那些在治疗组在任何时间点上周期14。















